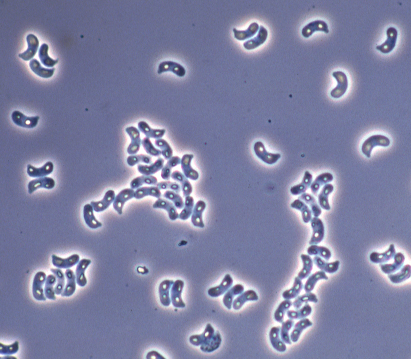

Hohenbuehelia cyphelliformis (Berk.) Miller (in Thorn 1986)

RGT #841013/01, on overwintered stems of burdock (Arctium minus) in old field, Dennison Farm, Opeongo Lake, Algonquin Provincial Park, Ontario, CANADA. The white to grey, distant lamellae, and habit of fruiting on somewhat woody, long-lived herbs (Clematis, Arctium, Heracleum) are distinctive. Photo October 13, 1984, copyright R.G. Thorn.
Basidiospores of RGT #841117/02, on Arctium in an old field, Lot 17, Concession 3, Eramosa Twp., Wellington Co., Ontario, CANADA. Photo November 1984, copyright R.G. Thorn.